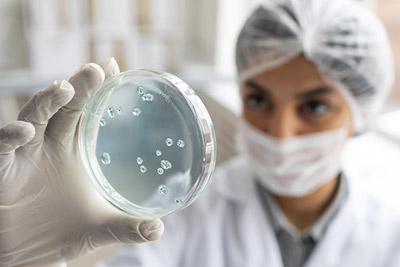

Befa Kozmetik
Hizmetlerimiz
Befa Cosmetics
Neden Biz?

Befa Cosmetics
Hakkımızda
Befa Kozmetik, 10 yılı aşkın tecrübesi ve deneyimli ekibiyle kozmetik, ortam kokulandırma ve biyosidal ürünlerle ilgili ihtiyaç duyulan her türlü formülasyon, ambalaj&etiket uygunluğu, fason üretim, kalite, laboratuvar test hizmetleri ve ruhsatlandırma süreçlerinin yurt içinde ve yurt dışında mevzuatlara uygun bir şekilde yürütülmesi ve takip edilmesi konusunda hizmet vermektedir. Befa, ülkemizde ve dünyada gerçekleşen değişiklikleri yakından takip edip mevzuat gerekliliklerini sizler için yerine getirmektedir.
- ÜTS Ürün Bildirim
- Mesul Müdür
- Fason Üretim
- Laboratuvar Hizmetleri
- Teknik Danışmanlık